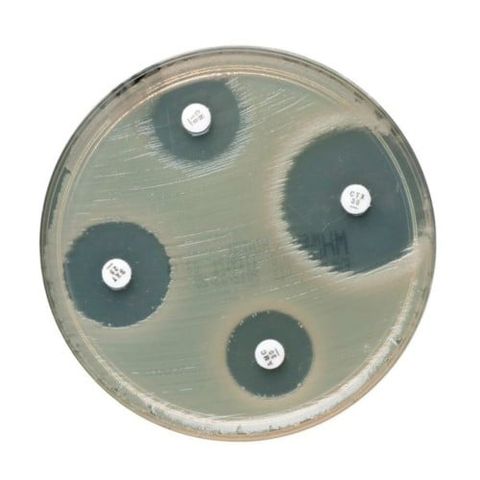

Manually determine the antibiotic susceptibility of microorganisms using Antimicrobial Susceptibility Testing (AST) methods in conjunction with reliable, easy-to-use Thermo Scientific™ Oxoid™ Gentamycin Antimicrobial Susceptibility Disks.
Description